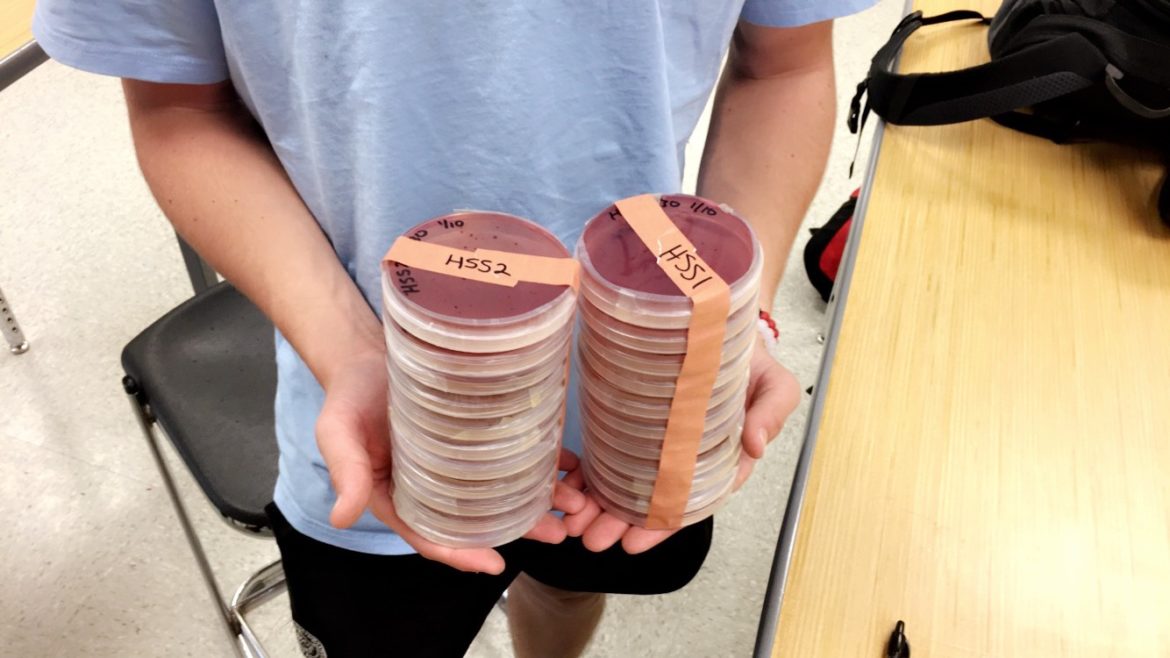
PARE-ing up with UGA

Pictured above are soil palettes each containing a variety of bacterial growth colonies. On Thursday, Feb. 17, the Clarke Central High School seventh period Advanced Placement Environmental Science class were to count these colonies as part of the ongoing Prevalence of Antibiotic Resistance Bacteria in the Environment (PARE) project. “Partnerships are formed between college undergraduate classrooms and high school science classes to bridge social and professional connections for both students and faculty, and I think this project is doing that,” Dr. Peggy Brickman, a professor for the department of plant biology at the University of Georgia said. Photo by Andrew Caldwell.
By ANDREW CALDWELL – Junior Copy Editor
On Feb. 17, University of Georgia professor Dr. Peggy Brickman revisited and updated the Clarke Central High School seventh period Advanced Placement Environmental Science class on the ongoing Prevalence of Antibiotic Resistance Bacteria in the Environment (PARE) project.
Dr. Peggy Brickman, professor of plant biology at the University of Georgia, announced to the Clarke Central High School seventh period Advanced Placement Environmental Science class on Jan. 17 and Jan. 18 that CCHS students would be participating in the Prevalence of Antibiotic Resistance Bacteria in the Environment (PARE) project.
Brickman returned to CCHS, along with her UGA undergraduate students on Feb. 17 to complete the final steps of this project. Her goal is to provide a pathway for instructors to implement research into their classrooms by finding out how many people might be exposed to antibiotic resistance bacteria from the environment.
“The soil collection that you all did a couple weeks ago, well now we’re going to be counting the bacterial colonies and entering that data into the database for me and my team,” Brickman said. “We plated the soil for you all and my undergrads will help you count because they’ve already done it before.”
Each group was paired with one of Brickman’s undergraduates, where students were given soil palettes and told to count each bacterial colony. Group members, along with the help of the undergraduates, then completed a chart and entered their data into an online database.
For senior Isobel Crain, this collaboration was meaningful.
“I think it was really fun that we got to incorporate UGA freshmen into our study because they have a deeper and much greater knowledge in what we are doing. It’s just interesting to just be with people that know more than us and the fact that we were able to work with different people who we don’t see everyday was a great experience,” Crain said. “I enjoyed how it was very collaborative.”
Science department teacher Claude Gonzalez was pleased by the accessibility and relatable nature of the project.
“This is cool. And you know what? This is what science is. This is what science does. We get these stereotypes in our heads of science being these white males in lab coats in a sterile environment talking sterilely to each other and being sterile. Most scientists I know drink a lot of beer and are really smart people and have fun with what they do. They actually think that what they’re doing is really, really, really cool stuff,” Gonzalez said.